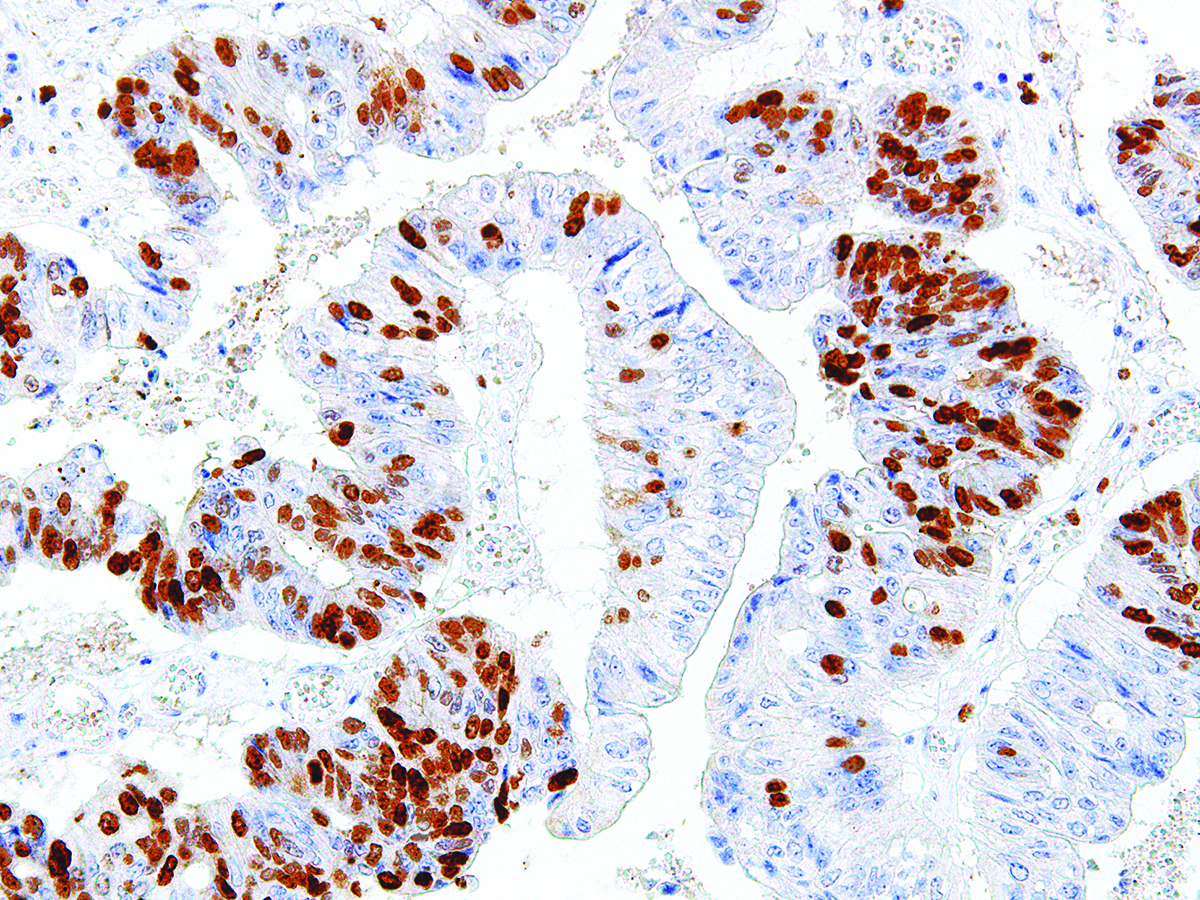

[Genomeme] Survivin
Cat. No.
IHC668-100
Specifications
| Clone | IHC668 |
| Source | Mouse Monoclonal |
| Positive Control | Lymphoma |
| Dilution Range | 1:100 - 1:400 |
Description
Survivin is an apoptosis inhibitor that is nearly undetectable in terminally differentiated cells, but found in most tumors including renal cell carcinoma, ovarian carcinoma, hepatocellular carcinoma, prostate carcinoma and breast carcinoma. Survivin expression is linked to tumor progression, but not patient survival.
'Genomeme' 카테고리의 다른 글
| [Genomeme] CD5 (0) | 2020.08.21 |
|---|---|
| [Genomeme] PSAP (0) | 2020.07.02 |
| [Genomeme] Annexin A1 (0) | 2020.01.16 |
| [Genomeme] CDX-2 (0) | 2019.12.31 |
| [Genomeme] CD45R (0) | 2019.12.24 |